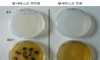

- 4월, 도서관에 ‘입덕’할 시간! 하남 9개 도서관 9…
- 하남시, 빅데이터 공모전 통해 ‘시민 체감형 정책’ 발…
- 박성현 광양시장 예비후보 “철동상 대신 시민”… 전 시…
- 고흥군, 1분기 현업종사자 대상 정기 안전보건교육 실시…
- 전남교육청, AI 기반 미래 진로교육 전환 속도 낸다
- 여수시의회, 여수문화재단 대표이사 후보자 인사청문회 개…
- 김영규, “정책은 더 전문적으로, 실행은 더 책임 있게…
- 여수시, 국동항 방치선박 정비·제재 본격 착수
- 여수시, 2026여수세계섬박람회 대비 도서지역 생활폐기…
- 시흥시, 세외수입·지방세정 평가 ‘쾌거’… 경기도 평가…

- 4월, 도서관에 ‘입덕’할 시간! 하남 9개 도서관 96색 독서문화행사 개막
- 하남시, 빅데이터 공모전 통해 ‘시민 체감형 정책’ 발굴 귀갓길 안전·보행환경 개선·공원 활용까지...데이터 기반 행정 본…
- 박성현 광양시장 예비후보 “철동상 대신 시민”… 전 시민 30만원 지원 추진 밝혀
- 고흥군, 1분기 현업종사자 대상 정기 안전보건교육 실시
- 전남교육청, AI 기반 미래 진로교육 전환 속도 낸다
- 여수시의회, 여수문화재단 대표이사 후보자 인사청문회 개최
- 김영규, “정책은 더 전문적으로, 실행은 더 책임 있게”
- 여수시, 국동항 방치선박 정비·제재 본격 착수
- 여수시, 2026여수세계섬박람회 대비 도서지역 생활폐기물 관리 강화
- 시흥시, 세외수입·지방세정 평가 ‘쾌거’… 경기도 평가서 최우수·도약상 수상
- 황사마스크, 황사 속 세균, 곰팡이 98% 제거
- 황사마스크, 황사 속 세균, 곰팡이 98% 제거
봄철 건조기에 편서풍을 타고 황사가 유입되는 날이 늘어가고 있다. 작년에 황사가 관측된 날은 하루(11월중)…
- 학생 눈높이에 맞춘 다양한 독도교육

- 학생 눈높이에 맞춘 다양한 독도교육
교육부(장관 서남수)는 이번 3월말에 발표된 일본의 고등학교 검정교과서의 역사왜곡에 대응하여 초‧중등학교…
- 내 집 앞에 도서관이 생겼어요

- 내 집 앞에 도서관이 생겼어요
경기도립중앙도서관(관장 신춘봉)은 학교 및 단체, 시각장애인 대상으로 찾아가는 도서관 서비스를 운영한다. 경기…
- 독서로 꿈 키우기

- 독서로 꿈 키우기
화도진도서관(관장 한태형)은 4월 2일부터 시각장애학생 독서능력 향상을 위해 ‘꿈자람 책놀이’ 프로그램을 운영한다.…
- 일본의 독도 영유권 침탈 행위, 강력히 규탄한다!
- 일본의 독도 영유권 침탈 행위, 강력히 규탄한다!
한국교원단체총연합회(회장 안양옥)는 일본 정부가 26일 독도를 일본 영유권으로 표현한 고교 사회과 교과서 검정결과를…
한국교원단체총연합회(회장 안양옥)는 일본 정부가 26일 독도를 일본 영유권으로 표현한 고교 사회과 교과서 검정결과를…
- 동대문도서관,힐링영어 프로젝트 운영
- 동대문도서관,힐링영어 프로젝트 운영
동대문도서관(관장 임갑식)은 청년취업준비생을 위한 '힐링영어' 제2탄을 다음과 같이 운영한다. - 기 간: 2…
동대문도서관(관장 임갑식)은 청년취업준비생을 위한 '힐링영어' 제2탄을 다음과 같이 운영한다. - 기 간: 2…
- 과천시, 청소년 어울마당 확대 운영
- 과천시, 청소년 어울마당 확대 운영
과천시는 청소년들의 꿈과 끼를 키워주기 위해 ‘청소년 어울마당’ 행사를 확대 운영하기로 했다. 그동안 중?고등…
과천시는 청소년들의 꿈과 끼를 키워주기 위해 ‘청소년 어울마당’ 행사를 확대 운영하기로 했다. 그동안 중?고등…
- 직장인을 위한 도서관 야간강좌 운영
- 직장인을 위한 도서관 야간강좌 운영
인천 동구(청장 조택상)는 주민들의 저녁 여가시간 활용을 돕고자 다음달 5일부터 2개월간 ‘2013년 송림도서관 야…
인천 동구(청장 조택상)는 주민들의 저녁 여가시간 활용을 돕고자 다음달 5일부터 2개월간 ‘2013년 송림도서관 야…
- 취업지원센터 1곳 더.. 특성화고 학생 위해
- 취업지원센터 1곳 더.. 특성화고 학생 위해
취업지원센터가 1곳 더 문을 연다. 특성화고 학생들의 취업을 위해 남부와 북부 등 2곳에서 물심양면 지원한다. …
취업지원센터가 1곳 더 문을 연다. 특성화고 학생들의 취업을 위해 남부와 북부 등 2곳에서 물심양면 지원한다. …
- 강원, 학부모지원센터, 고충 상담등 지원 기능 강화
- 강원, 학부모지원센터, 고충 상담등 지원 기능 강화
강원도교육청(교육감 민병희)은 2013년 학부모지원센터 운영 계획을 확정하고, 자녀교육 관련 상담, 찾아가는 학부모…
강원도교육청(교육감 민병희)은 2013년 학부모지원센터 운영 계획을 확정하고, 자녀교육 관련 상담, 찾아가는 학부모…
- 오산시, 청소년지도위원 위촉식 개최

- 오산시, 청소년지도위원 위촉식 개최
경기 오산시(시장 곽상욱)는 지난 22일 오후 시청 물향기실에서 청소년유해환경정화와 청소년선도·보호 활동의 파수꾼인…
- 사립유치원 납입금 안정화 추가 대책 발표
- 사립유치원 납입금 안정화 추가 대책 발표
수원지역 사립유치원들이 정부의 납입금 안정화 방침에 적극 동참할 것을 밝힌 가운데, 경기도교육청(북부청사)은 일부 …
수원지역 사립유치원들이 정부의 납입금 안정화 방침에 적극 동참할 것을 밝힌 가운데, 경기도교육청(북부청사)은 일부 …
- 연천경찰서 명예경찰소년단 발대식

- 연천경찰서 명예경찰소년단 발대식
연천경찰서(서장 김사웅)는 지난 21일(목) 15:00 연천경찰서 강당에서 다문화가정 자녀가 참여하는 2013년 명…
- “인천 최초” 독거노인 U-Care 시스템 가동

- “인천 최초” 독거노인 U-Care 시스템 가동
인천 동구(청장 조택상)가 3월부터 인천 최초로 독거노인 1,000세대를 대상으로한 독거노인 U-Care 시스템을 …
실시간 HOT 뉴스
- 14월, 도서관에 ‘입덕’할 시간! 하남 9개 도…
- 2하남시, 빅데이터 공모전 통해 ‘시민 체감형 정…
- 3박성현 광양시장 예비후보 “철동상 대신 시민”……
- 4고흥군, 1분기 현업종사자 대상 정기 안전보건교…
- 5전남교육청, AI 기반 미래 진로교육 전환 속도…
- 6여수시의회, 여수문화재단 대표이사 후보자 인사청…
- 7김영규, “정책은 더 전문적으로, 실행은 더 책…
- 8여수시, 국동항 방치선박 정비·제재 본격 착수
- 9여수시, 2026여수세계섬박람회 대비 도서지역 …
- 10시흥시, 세외수입·지방세정 평가 ‘쾌거’… 경기…
